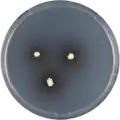
Aspergillus iizukae growing on CYA plate

Aspergillus iizukae
| Aspergillus iizukae | |
|---|---|
| Scientific classification | |
| Kingdom: | Fungi |
| Division: | Ascomycota |
| Class: | Eurotiomycetes |
| Order: | Eurotiales |
| Family: | Aspergillaceae |
| Genus: | Aspergillus |
| Species: | A. iizukae
|
| Binomial name | |
| Aspergillus iizukae Sugiyama (1967)[1]
| |
Aspergillus iizukae is a species of fungus in the genus Aspergillus. It is from the Flavipedes section.[2] The species was first described in 1967.[1]
Growth and morphology
A. iizukae has been cultivated on both Czapek yeast extract agar (CYA) plates and Malt Extract Agar Oxoid® (MEAOX) plates. The growth morphology of the colonies can be seen in the pictures below.
-
Aspergillus iizukae growing on CYA plate
Aspergillus iizukae growing on CYA plate -
 Aspergillus iizukae growing on MEAOX plate
Aspergillus iizukae growing on MEAOX plate
References
- ^ a b Sugiyama, J. 1967, J. Fac. Sci. Univ. Tokyo, Sec. 3 9: 390
- ^ Hubka, Vit; Nováková, Alena; Kolarik, Miroslav; Jurjevic, Zeljko; Peterson, Stephen W. (2015). "Revision of Aspergillus section Flavipedes: seven new species and proposal of section Jani sect. nov". Mycologia. 107 (1): 169–208. doi:10.3852/14-059. PMID 25344259.